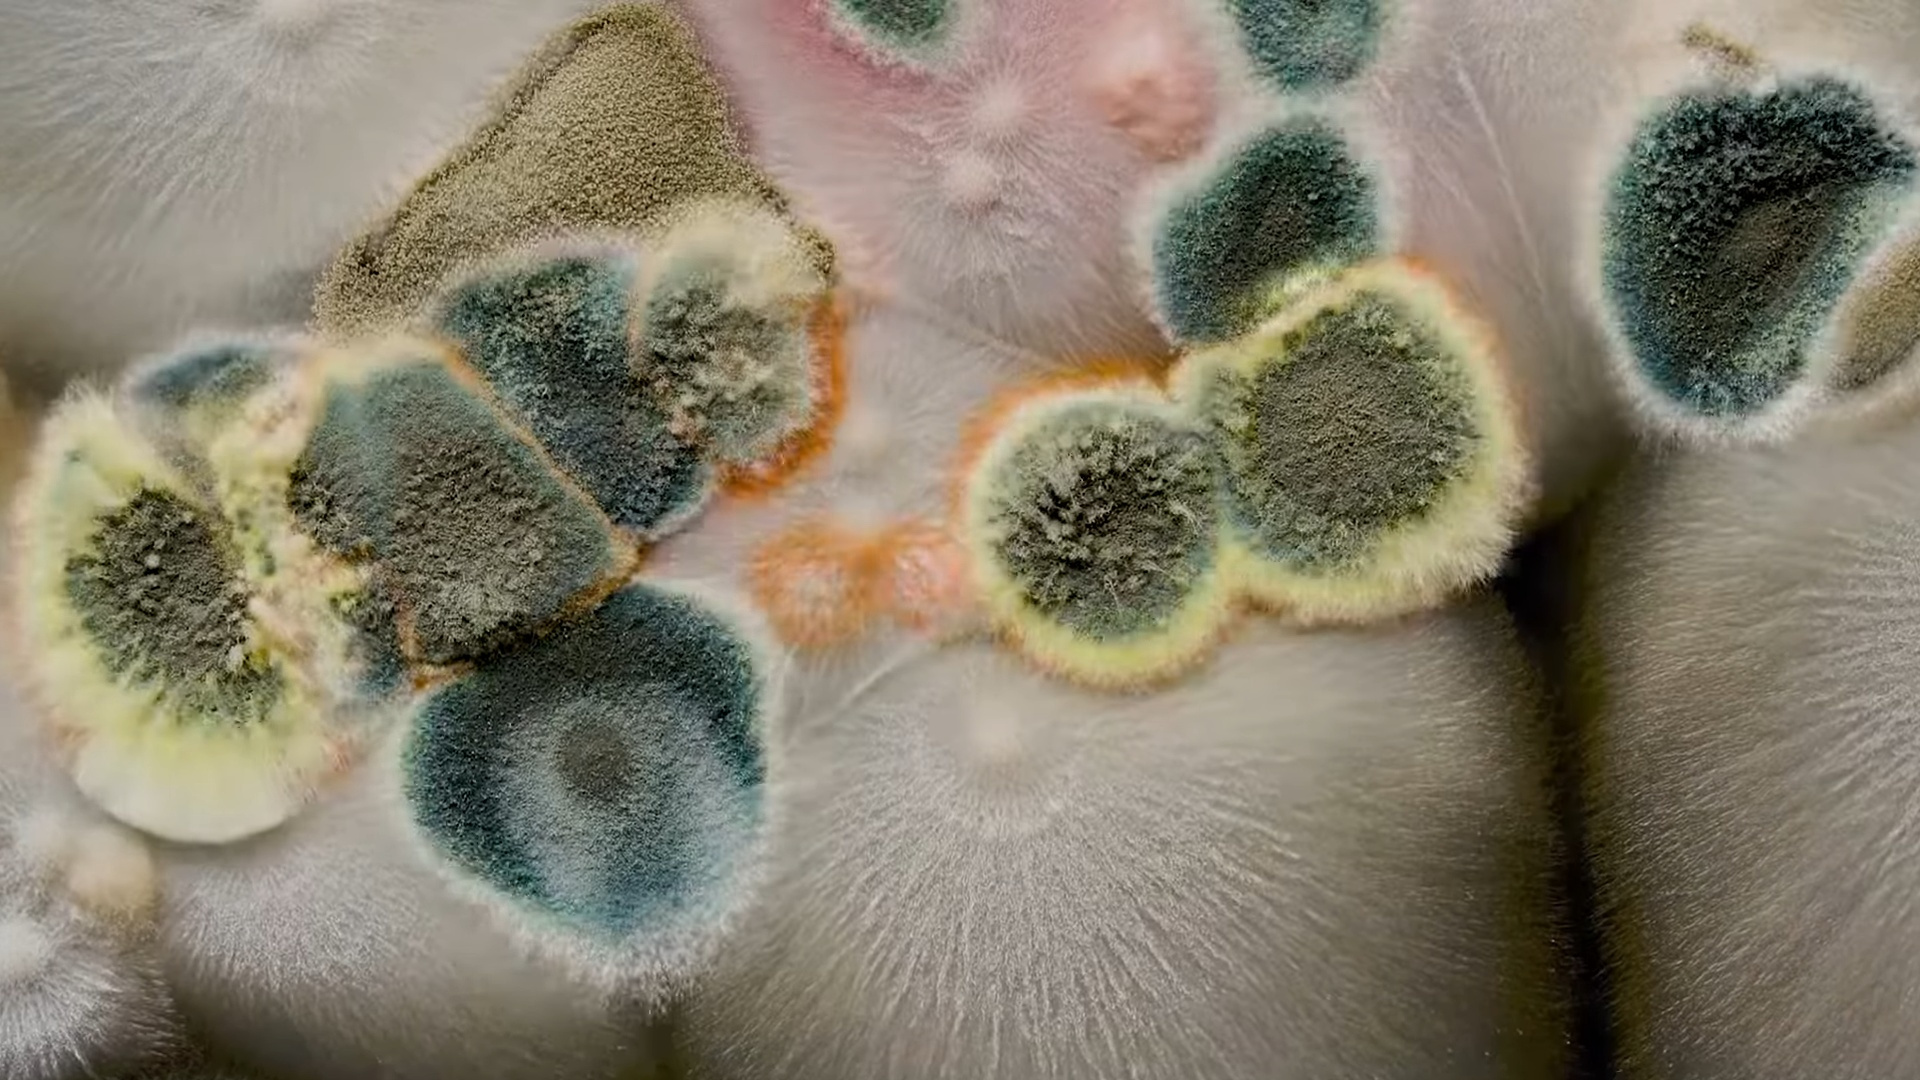

Ne visai augalas, ne visai gyvūnas, bet kažkas tarp jų. Grybai – itin įdomus mokslininkų tyrimų objektas, kuris, tikėtina, vis dar slepia svarbiausias gamtos paslaptis. Vedami magiško Björk balso ir britų biologo ekspertizės, įsitrauksite į be galo turtingą grybų tinklą bei panirsite į požeminio pasaulio stebuklus, egzistuojančius nuo dinozaurų laikų. Galbūt būtent grybai yra sprendimas didžiausioms mūsų žemės problemoms?

6.4
6.4


 30%
30%



 85
85

